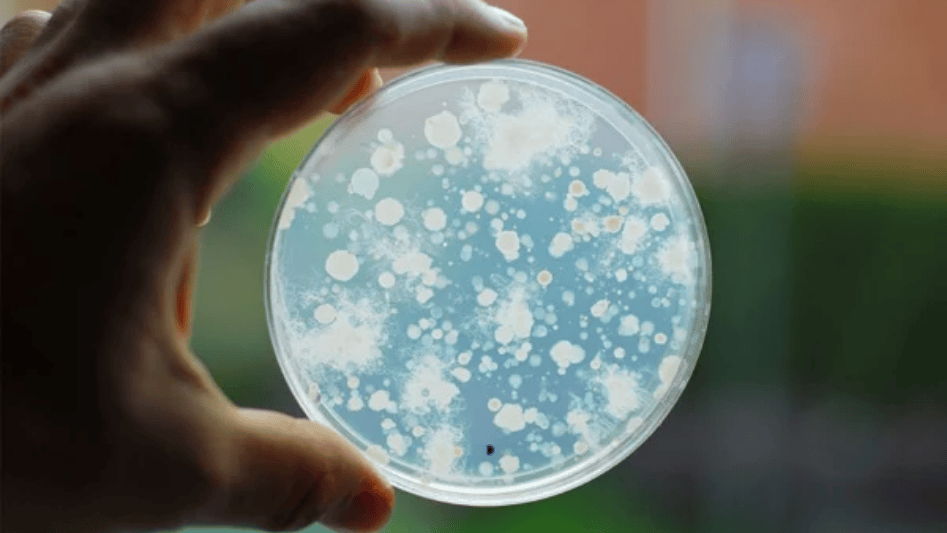
Hand holding a microbial count plate.

Advantages of Using Microbial Count Plates in Rapid Microbiological Testing
Rapid microbiological testing is essential to guaranteeing safety and compliance in the hectic fields of pharmaceuticals, food safety, and healthcare. These industries rely heavily on












